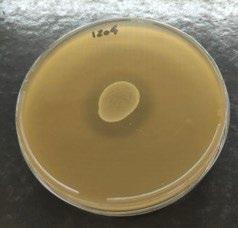

Una salud
Perspectiva sobre la problemática de la resistencia a antibióticos pg. 1




Desde hace algunos años, el concepto “One Health” (del inglés, “Una Salud”) parece ir de la mano con el tema de la resistencia a los antibióticos como la solución más integral y global a esta problemática.
La resistencia a los antimicrobianos, conocida como RAM, se da cuando los microorganismos como las bacterias y los hongos desarrollan la capacidad de tolerar a los medicamentos utilizados para eliminarlos. Este es un problema que afecta no solo a las personas, sino también a los animales, las plantas y el medio ambiente.
El uso de antimicrobianos en cualquier lugar, como en un hospital o en una granja, puede contribuir a la RAM, lo que hace que las infecciones tanto en personas como en animales sean más difíciles de tratar.
El interés por el tema de la resistencia a los antibióticos y el enfoque One Health se ha establecido en gran medida en los últimos años por un número creciente de estudios que reconocen vínculos entre una pluralidad de dominios (salud humana, salud animal, medio ambiente y alimentación), tras el surgimiento de crisis sanitarias y alimentarias internacionales y sus consecuencias están siendo abordadas por diversas partes interesadas, incluidas las autoridades públicas, los líderes políticos y los agentes económicos.
A partir de esta perspectiva, y con un compromiso por parte de todos los actores, podemos confiar en que se mejorarán en gran medida los parámetros seguridad de los alimentos y el agua, la nutrición, el control de las zoonosis, la gestión de la contaminación y la lucha contra la resistencia a los antimicrobianos.
EDITOR
GRUPO DE COMUNICACIÓN AGRINEWS S.L. PUBLICIDAD
Anna Fernández Oller +34 609 14 50 18 af@agrinews.es
Luis Carrasco +34 605 09 05 13 lc@agrinews.es
Victoria Domingues +55 41 992091549 nutrisocial@grupoagrinews.com
DIRECCIÓN TÉCNICA
José Ignacio Barragán (aves) David Solà-Oriol (porcino) Fernando Bacha (rumiantes)
COORDINACIÓN TÉCNICA
Ayelén Chiarle nutrilatam@grupoagrinews.com
Osmayra Cabrera Daniela Morales María de los Ángeles Gutiérrez
COLABORADORES
Carlos De Blas (UPM) Gonzalo Glez. Mateos (UPM) Xavier Mora (Consultor) Alfred Blanch (Consultor) Alba Cerisuelo (CITA-IVIA) Carlos Fernández (UPV)
ADMINISTRACIÓN

Inés Navarro
Tel: +17866697313 info@grupoagrinews.com www.nutrinews.com
Precio de suscripción anual: 90 USD
La dirección de la revista no se hace responsable de las opiniones de los autores. Todos los derechos reservados. Imágenes: Dreamstime
ISSN (Revista impresa) 2696-810X ISSN (Revista digital) 2696-8118
GRATUITA PARA FABRICANTES DE ALIMENTO BALANCEADO, EMPRESAS DE PREMIXES Y NUTRICIONISTAS Depósito Legal Nutrinews B-17990-2015
4
Materias primas: Grasa Animal
Alba Cerisuelo IVIA
Relación entre aditivos alimentarios y el perfil de ácidos grasos en pollos
Aleksandro Schafer da Silva2, Gabriela Miotto Galli 1 e Ines Andretta1 1 Departamento de Ciência Animal, Universidade Federal do Rio Grande do Sul - UFRGS, Porto Alegre, RS, Brasil.
2 Departamento de Ciência Animal, Universidade do Estado de Santa Catarina-UDESC, Chapecó, SC, Brasil Michael Noonan Business Development Manager Perstorp Animal Nutrition
Gerardo Villalobos S. M.V. Msc. Nuproxa Switzerland Ltd.
42
48


Evaluación de la actividad antagonista de Floramax-B11TM frente a aislamientos de Escherichia coli (APECS) multirresistentes a antimicrobianos

M.V. Fabrizio Matte –Coordinador
Técnico Vetanco Brasil
Caracterización nutricional de la arveja (Pisum sativum) para la alimentación de las aves y efecto del desactivado con microondas

Iglesias BF 1 , Charrière MV 1 , Gaggiotti M2, Fain Binda V 1 , Chale J 1 , Prieto GM3
1 Sección Avicultura, INTA-EEA Pergamino; 2 Laboratorio de Forrajes, INTA-EEA Rafaela; 3 AER Arroyo Seco, INTA-EEA Olivero
Importancia de la dieta porcina para producir carne de cerdo aceptable 56

S.Millet, M.Aluwé ILVO, Melle, Belgium
Control integrado de nematodos gastrointestinales en pequeños rumiantes 66


Rafael Arturo Torres-Fajardo 1 , Rosa Isabel Higuera-Piedrahita 2 1 Universidad Autónoma de Yucatán, Facultad de Medicina Veterinaria y Zootecnia, Yucatán, México. 2 Universidad Nacional Autónoma de México. Facultad de Estudios Superiores Cuautitlán. Cuautitlán. México
Las grasas de origen animal son materias primas que proceden en su gran mayoría del sacrificio de animales terrestres, incluidos los invertebrados. Esta categoría también incluye, por lo tanto, la grasa procedente de insectos. Quedan fuera de esta definición las grasas procedentes de pescados y sus subproductos.

A pesar de ser un subproducto de origen animal, el uso de grasas animales en alimentación animal no ha estado sujeto a la prohibición que afectó a otros productos como las harinas cárnicas hasta el pasado año.



Actualmente, estas pueden utilizarse con independencia de su origen tanto en animales monogástricos como en animales rumiantes, aunque su uso en rumiantes es más limitado debido al efecto tóxico de las grasas sobre la microbiota del rumen.

En general, según su punto de fusión, las grasas se clasifican en (Feedipedia, 2012):
El sebo procede de animales rumiantes.
La manteca procede principalmente de porcino, aves o caballos.
Los aceites suelen proceder de animales marinos o vegetales (no se incluyen en la definición de grasas animales).

Además, las grasas animales pueden comercializarse como mezcla de varios tipos de grasa.
Las grasas animales aportan fundamentalmente energía en forma de lípidos a los alimentos. sebos (sólidas a temperaturas > 40ºC), mantecas (sólidas a temperaturas entre 20 y 40ºC) y aceites (líquidas a temperaturas >20ºC)
De manera obligatoria es necesario declarar el contenido en grasa bruta y humedad cuando este es superior al 1%.
El “Catálogo de materias primas” (Reglamento (UE) 68/2013) clasifica la grasa animal en el apartado “9. Productos de animales terrestres y sus productos derivados” (Tabla 1).
Tabla 1. Clasificación de la grasa animal según el Catálogo de Materias Primas (Reglamento (UE) 68/2013).
9.2.1
Grasa animal1 Producto compuesto de grasas de animales terrestres en todas las etapas de su vida, incluidos los invertebrados, salvo los de especies patógenas para los seres humanos o los animales. Si se extrae mediante disolventes, puede contener hasta un 0,1 % de hexano.
Grasa bruta Contenido de humedad, cuando sea > 1 %.
1 Sin perjuicio de los requisitos obligatorios relativos a los documentos comerciales y los certificados sanitarios para subproductos animales y productos derivados según lo establecido en el Reglamento (UE) n. o 142/2011 (capítulo III del anexo VIII), si el catálogo se utiliza a efectos de etiquetado, la denominación se completará según proceda con: — la especie animal transformada (por ejemplo, porcinos, rumiantes, aves de corral, insectos), y/o — la fase del ciclo vital (por ejemplo, larvas) o — la materia prima transformada (por ejemplo, huesos) y/o — el tratamiento utilizado (por ejemplo, desengrasado, refinado) y/o — la denominación de la especie animal no utilizada en relación con la prohibición de reciclado dentro de la misma especie (por ejemplo, no contiene aves de corral).
En general, las grasas de origen animal se obtienen de mataderos autorizados a partir de subproductos categorizados como SANDACH de categoría 3, que son los Subproductos Animales No Destinados al Consumo Humano de menor riesgo.
Estos consisten en recortes que se realizan en las canales y otras fracciones grasas, que son transformadas a nivel industrial.
En el proceso de transformación, estos ingredientes deben tratarse según lo dispuesto en la sección 3 del capítulo II del Anexo X del Reglamento (EU) 142/2011.
En general, estos productos deben someterse a unos procedimientos que combinan temperatura y presión durante un tiempo determinado para conseguir una correcta higienización del producto.






Desde un punto de vista químico, tanto los aceites como las grasas son triglicéridos (ésteres de ácidos grasos y glicerol) que se diferencian entre sí por los ácidos grasos que se unen al glicerol.
La calidad y valor nutricional de las diferentes fuentes de grasa animal dependen de varios factores. Entre estos factores que afectan a su calidad química y estabilidad (a menudo relacionados con su manipulación durante la obtención y conservación) destacan
su pureza (contenido en impurezas como partículas de fibra, pelos, piel, huesos, tierra), cantidad de lípidos insaponificables, presencia de ácidos grasos libres, cantidad de peróxidos o presencia de tóxicos (dioxinas).
Además, las características propias de cada tipo de grasa en términos de longitud de la cadena de ácidos grasos o grado de saturación están directamente relacionados con la calidad nutricional (valor energético) de éstas.
En este sentido, cuanto más corta es la cadena de ácidos grasos y mayor el porcentaje de insaturación mayor será el valor energético, especialmente en el caso de animales monogástricos
En el caso de animales rumiantes, los ácidos grasos poliinsaturados de cadena larga (> 20 C) son más tóxicos para los microorganismos ruminales que los ácidos grasos de cadena intermedia, por lo que pueden reducir la digestibilidad de otros nutrientes.
Los ácidos grasos de cadena corta (< 14 C) y los de cadena muy larga (> 20 C) tienen una menor digestibilidad que otros ácidos grasos en rumiantes.
En la Tabla 2 se incluye la composición publicada por FEDNA e INRAE-CIRAD-AFZ del sebo, manteca y grasa de aves.
En general, se considera que estos ingredientes están compuestos por un 100% de grasa y no contienen humedad, proteína o aminoácidos o minerales (o su contenido es mínimo en estos nutrientes).

Los ácidos grasos mayoritarios en cada fuente son diferentes, siendo característico el bajo nivel de linoleico en el sebo, consecuencia del metabolismo ruminal, y elevado el nivel de ácidos grasos insaturados en la manteca o grasa de pollos.
A nivel energético, se considera un valor de energía bruta similar entre las diferentes fuentes, alrededor de 39 MJ/kg de materia seca.
Entre especies, la energía metabolizable (EM) cambia, como es lógico, pero también según la fuente consultada.
A modo de ejemplo, comparando las dos fuentes utilizadas en esta ficha se observa cómo mientras la EM para porcino es similar entre fuentes, la EM para rumiantes y aves es inferior a la de porcino en las tablas FEDNA y superior en las tablas INRAE-CIRAD-AFZ.
Digestión de proteínas

Proteína Peptidos Aminoácidos
La valoración energética de las grasas es complicada y a su vez muy variable.
1
Tabla 2. Composición química (en materia seca) de diferentes tipos de proteínas animales procesadas
FUENTES INRAE-CIRAD-AFZ (2017-2021)1 FEDNA (2019) 2
Materias primas Sebo Manteca de cerdo Grasa de aves Sebo Manteca de cerdo Grasa de aves
Materia seca % 100 100 100 100 100 100
Proteína bruta % 0 0 0 0 0 0 FB % 0 0 0 0 0 0 FND % 0 0 0 0 0 0 FAD % 0 0 0 0 0 0 LAD % 0 0 0 0 0 0 Grasa bruta % 100 100 100 100 100 100 Almidón % 0 0 0 0 0 0 Cenizas % 0 0 0 0 0 0 Calcio % 0 0,1 0 0 0 0 Fósforo % 0 0,3 0 0 0 0
EB MJ/kg MS 39,3 39,3 39,3 - -EM rum MJ/kg MS 36,7 36,7 36,7 28,3 28,8 28,4
EM porc (growing) MJ/kg MS 33,2 33,2 34,4 33,6 34,7 35,7 EN porc (growing) MJ/kg MS 29,8 29,7 30,8 31,4 32,4 33,2 EMn pollos MJ/kg MS 30,2 34,5 36,9 29,7 32,6 33,4 Acidos grasos saturados3
Láurico, 12:0 % 0,18 0,15 0,1 - -Mirístico, 14:0 % 3,15 1,69 1,02 3,14 1,47 0,98 Palmítico, 16:0 % 26,3 24,8 21,3 24,5 23,2 21,2 Esteárico, 18:0 % 21,2 15,4 7,41 20,1 12,7 7,25 Ácidos grasos monoinsaturados3
Palmitoléico, 16:1n-7 % 3,81 2,82 4,66 3,14 2,94 5,29 Oléico, 18: 1n-9 % 38,5 43,2 43,3 37,5 43,1 43,1 Ácidos grasos poliinsaturados3
Linoléico, 18:2n-6 % 2,76 9,49 19,1 2,16 9,80 18,6 Linolénico, 18:3n-3 % 0,65 0,84 1,48 0 0,78 1,38 Eicosapentaenóico, 20:5n-3 % 0 0 0 - -Docosahexaenóico, 22:6n-3 % 0 0 0 - - -
https://feedtables.com/content/table-dry-matter; valores expresados en materia seca 2 http://www.fundacionfedna.org/ingrediente; valores expresados en materia seca
Materias primas: Grasa
El aceite de insectos es otro tipo de grasa que está también disponible en la actualidad para alimentación animal y que se englobaría dentro de la categoría de grasa animal.



Su valor nutricional para las diferentes especies de abasto no está todavía definido en las diferentes tablas de alimentos.
Estudios recientes indican que el aceite de gusanos contiene una elevada proporción de C12:0. Sin embargo, la grasa del gusano de la harina o del grillo son ricas en C16:0, C18:1n-9 y C18:2n-6 (Jayanegara et al. 2020).
Mientras que el perfil de la mosca soldado negra es más saturado y contiene una elevada cantidad de C12:0 y moderadas de C16:0, C 18:1 ω9 y C18:2 ω6 (Kim et al., 2020).
Por lo tanto, la composición del aceite de insecto depende de manera relevante de la especie de origen.

La inclusión de grasa en los alimentos para animales tiene una función energética fundamentalmente.
El incremento de calor metabólico de la grasa es bajo, y por ello la inclusión de grasa en alimentos es una estrategia que se utiliza , fundamentalmente, en épocas de calor.

También es bien conocido que la inclusión de grasa en los alimentos de monogástricos mejora la transformación de los alimentos ya que provee de nutrientes esenciales (ácidos grasos esenciales como el linoleico conjugado, linolénico o araquidónico) y facilita la absorción de las vitaminas liposolubles.
Esto puede ser propio de cualquier tipo de grasa.
Como ya se ha comentado, la situación en animales rumiantes es algo diferente ya que ciertos tipos de grasas a niveles determinados pueden ser tóxicos para los microorganismos del rumen (Jayanegara et al., 2020).
Sin embargo, además de su función nutricional, merece la pena destacar que las grasas tienen otras funciones como mejorar la palatabilidad, la textura y presentación del alimento en harina y la granulación (dentro de unos límites).
Por otro lado, es importante mencionar que en los animales monogástricos, el suministro de lípidos a través de la dieta influye en la cantidad de su depósito graso y el perfil de ácidos grasos de sus reservas grasas y magras de los huevos.
Esto ofrece la ventaja de poder manipular el perfil de ácidos grasos de las canales y de los huevos (ej. enriquecimiento en ácidos grasos esenciales como el omega 3) (Chiba et al., 2020).
Sin embargo, en ocasiones esto puede plantear problemas de canales aceitosas o estabilidad oxidativa de la grasa de la canal si la inclusión de ciertos ingredientes no se controla, especialmente en las últimas fases del cebo.
Estudios recientes indican que, además, ciertos ácidos grasos (n-3 poliinsaturados de cadena larga) en el alimento o las grasas de insectos pueden ejercer un efecto sobre el sistema inmune de los animales y su salud intestinal (Karaffová et al., 2022; Kieronczyk et al., 2022).
En los animales rumiantes, sin embargo, el metabolismo del rumen impide que los ácidos grasos sean depositados tal cual se ingieren y son transformados en el rumen a ácidos grasos saturados.



En conclusión, las grasas animales son una excelente fuente de energía y nutrientes esenciales, que además puede contribuir a la sostenibilidad de la ganadería.

Sin embargo, es necesario unificar criterios en la asignación de su valor energético y estudiar más a fondo fuentes alternativas y prometedoras como son el aceite de insectos y sus efectos sobre la salud intestinal y general de los animales.
 Materias primas: Grasa animal DESCÁRGALO EN PDF
Materias primas: Grasa animal DESCÁRGALO EN PDF
Los piensos sanos y seguros son esenciales para obtener alimentos sanos y seguros, por lo que es importante contar con un sistema de higiene de piensos eficiente que minimice el riesgo de contaminación bacteriana patógena. Para las empresas, el retiro de
un producto es costoso y perjudicial para su reputación. Para los productores de piensos, también podría significar detener la producción y realizar una descontaminación conjuntamente con la eliminación de piensos y materiales.
 Michael Noonan, Business Development Manager Perstorp Animal Nutrition
Michael Noonan, Business Development Manager Perstorp Animal Nutrition
Cuando hay un riesgo de contaminación por bacterias patógenas, se deben tomar medidas para minimizar los posibles peligros. El uso de métodos efectivos para prevenir la contaminación y la recontaminación de los alimentos es importante tanto para el rendimiento animal como para la industria de piensos.

En el pasado, el formaldehído ofrecía una solución muy eficaz contra la Salmonella en los piensos. Sin embargo, al estar registrado como carcinógeno, fue prohibido en Europa en el 2018. El mundo ahora espera nuevas soluciones.
Las soluciones de higiene de piensos a base de ácidos orgánicos y tratamiento térmico se consideran actualmente las alternativas más eficientes. Perstorp, productor sueco de aditivos ha investigado la efectividad de otras moléculas y combinaciones de moléculas contra patógenos en los alimentos durante décadas. Se ha descubierto que se logran resultados óptimos combinando un tratamiento térmico moderado junto con aditivos optimizados que evitan la recontaminación después del tratamiento térmico. Este es un hallazgo respaldado en estudios
REGLAMENTO (CE) No. 183/2005 menciona todas las normas de la cadena alimentaria. Lo que se acepta comúnmente es que tanto el pienso como las materias primas no deben contener Salmonella en una muestra de 25 gramos. Cada año en la UE, entre el 1,8% y el 1,9% de las muestras analizadas son positivas para Salmonella.

Aunque la Salmonella está en el centro de atención, las fábricas deben pensar en la contaminación por enterobacterias como un todo. Si solo se enfocan en una bacteria específica, es posible que se pasen por alto otras que también están teniendo un efecto
El tratamiento térmico permite reducir la carga bacteriana en el proceso de fabricación del alimento, mientras que determinados ácidos orgánicos previenen frente a re contaminaciones en la misma fábrica y durante su almacenaje.
Tanto el tratamiento térmico como las soluciones de higiene de los piensos son eficaces para reducir la carga de enterobacterias. Sin embargo, cuando el alimento se trata térmicamente, también se eliminan algunas bacterias benéficas. Esta destrucción de la flora da lugar a que bacterias patógenas recontaminen el alimento.

Cuando solo se usa tratamiento térmico, el pienso terminado se recontamina fácilmente durante el enfriamiento y/o secado. La condensación dentro de la maquinaria y el aire cargado de impurezas permitirán que crezcan bacterias como la E. coli.
Las soluciones de higiene de los piensos ayudarán a los productores de piensos a mantenerse seguros. Cuando estos productos se

Para probar la eficiencia de los ácidos orgánicos junto con el tratamiento térmico, se llevó a cabo un estudio SYTTAC en Tecaliman en Francia. El pienso se contaminó a propósito con log5 enterobacterias para estandarizar los niveles iniciales de contaminación.
Se agregó ProPhorce™ SA Exclusive de Perstorp (4 kg/T) al pienso, el cual se le hizo un tratamiento térmico a 3 temperaturas diferentes o que no tuvo tratamiento térmico en absoluto. Se midieron las cargas de enterobacterias (inicial, antes del proceso de enfriamiento, después del proceso de enfriamiento).
Los resultados se compararon con una muestra control en condiciones de referencia: sin acidificante, calentada a 80° C durante 2 minutos.
El gráfico (Figura 1) muestra que, si el pienso no se calienta en absoluto, la carga de enterobacterias se mantiene bajo control (reducción de 1/2log). Cuando se calienta a 55° C, se observa una reducción log1 que es suficiente en la mayoría de los casos para garantizar la limpieza del proceso.
No temperatura ProPhorce™ SA Exclusive (4 kg/T)

temp. 55° 2mn ProPhorce™ SA Exclusive (4 kg/T)
temp. 65° 2mn ProPhorce™ SA Exclusive (4 kg/T)
temp.80° 2mn ProPhorce™ SA Exclusive (4 kg/T)
temp.80° 2mn Sin acidi cante
Figura 1 . Efectividad de ProPhorce™ SA Exclusive para reducir la carga de enterobacterias en el alimento, con y sin tratamientos térmicos. (Gráfico de carga de enterobacterias del estudio SYTTAC - 2012)
Entonces, una temperatura de 65° C será lo suficientemente alta como para inactivar las enterobacterias sin destruir algunos de los frágiles nutrientes dentro del alimento (80° C - 2 min son condiciones severas para algunos nutrientes).
En todos los casos, la adición de ProPhorce™ SA Exclusive evita que el recuento de enterobacterias aumente después del enfriamiento. Por el contrario, existe una clara evidencia de la recontaminación de enterobacterias en la muestra control negativo que demuestra que el tratamiento térmico por sí solo genera una situación de riesgo.
En la era post-formaldehído, los fabricantes de piensos y los productores de aves de corral necesitan reconsiderar su estrategia de higiene de los piensos. Los ácidos orgánicos que se utilizan para tratar piensos ahora están oficialmente aprobados para reducir en los piensos

En los últimos años, la bioseguridad en la agricultura ha ganado importancia gracias al mayor enfoque en el rendimiento animal y la seguridad alimentaria.
Dados los peligros microbiológicos que pueden introducirse en varios puntos de la producción de piensos balanceados, las tecnologías deben ser efectivas para reducir los niveles bacterianos y brindar protección contra la recontaminación.
Los productos ProPhorce™ Feed Hygiene reducen la contaminación por enterobacterias, incluida la Salmonella, y ayudan a prevenir la recontaminación.


Es importante encontrar soluciones de higiene de piensos de largo plazo que se puedan integrar con el control bacteriano en la cadena alimentaria. De esta forma, las empresas están protegidas y los consumidores confían en los productos que adquieren.
El Arte de la higienización de piensos DESCÁRGALO EN PDF


 Gerardo Villalobos S. M.V. Msc. Nuproxa Switzerland Ltd.
Gerardo Villalobos S. M.V. Msc. Nuproxa Switzerland Ltd.
Mucho se habla y muy a menudo sobre el uso de productos naturales para mantener y mejorar la salud intestinal, especialmente desde que en muchos países se ha ido prohibiendo el uso de Antibióticos como Promotores del Crecimiento (APC´s) en la producción animal.

Cada día la lista de productos prohibidos o no deseados se va haciendo más larga.
Así mismo va creciendo el interés de productores y veterinarios por conseguir alternativas naturales que verdaderamente cubran sus expectativas en el control y reducción de patógenos intestinales, sosteniendo y mejorando la microbiota y generando beneficios y mejoras en los parámetros zootécnicos y sobre todo que generen una buena relación costo beneficio.

Viendo el panorama descrito, la aparición de productos de origen natural para la sustitución de los antibióticos promotores de crecimiento (APC) se ha convertido en una carrera acelerada de investigación, desarrollo y mercadeo entre grandes empresas farmacéuticas, de medicina Ayurvédica y de biotecnología con el objetivo de conseguir soluciones reales y un posicionamiento en un mercado del cual se sabe que quiere y necesita cambios.

A lo anterior hay que considerar que el mundo está cambiando y con ello la percepción, la conciencia y los hábitos de los consumidores en relación con los sistemas de producción y el bienestar animal, la ingestión de alimentos más saludables, sin químicos y por supuesto proteína animal libre de antibióticos ni aditivos químicos y que además no cueste más.
Todo esto, indudablemente hace más difícil no solo producir eficientemente sino de manera rentable en un mercado por demás globalizado y mucho más competitivo.


Muchas veces se tiende a generalizar el término de producto natural, pero existe una amplísima variedad de productos con aplicaciones y funcionalidades diversas y objetivos distintos, de calidad variable y que, si bien son de origen natural, no todos lo son al 100% por intervenir procesos y solventes químicos en su método de extracción.
También están las Oleorresinas que son las más empleadas para la concentración de elementos contenidos en las especias mediante el uso de solventes volátiles como hexano, acetona, acetato de etilo, etc.

Entre los productos de origen natural se encuentran:
Probióticos Prebióticos y combinaciones de ambos denominados Simbióticos
También dentro de los productos denominados naturales encontramos los Ácidos Orgánicos con amplio uso en la industria alimentaria y en la salud animal.
Existen también productos que se obtienen por destilación para obtener las sustancias más volátiles de las plantas y a los que se les denomina Aceites Esenciales, y para los cuales se pueden usar no solo semillas sino
Por último, encontramos a los Productos Herbales, estos provienen de mezclas o combinaciones de plantas.
Básicamente son compuestos de una o varias partes de diferentes plantas y cuya característica principal radica en que para su elaboración solo se emplean métodos físicos: secado, triturado y molido o pulverizado, pero siempre en su estado natural y como no sufren ningún tipo de proceso o extracción química.


Es importante señalar que en la producción orgánica (tanto pollos como huevos) para poder conservar el estatus de orgánico y ser catalogado como tal, no pueden usar dentro de los ingredientes de sus alimentos o materias primas ningún producto que tenga implícito un proceso químico dentro de su elaboración.


Es importante resaltar, que existen diferencias bien marcadas entre un producto extraído de plantas y un producto herbal con sus elementos tal cual los encontramos en la naturaleza.
Para todos los casos, la intención de los productos naturales de origen vegetal es aprovechar los atributos y propiedades específicas que hoy en día son bastante conocidos en los diferentes fitoquímicos
En esto último es donde reside la gran eficiencia y el complejo entendimiento de los múltiples mecanismos de acción que tienen los productos herbales, ya que este tipo de producto al ser en su mayoría de origen poli-herbal contienen complejas y múltiples asociaciones de fitoquímicos.
Estos trabajan de manera
Los productos de herbales son tan diversos y diferentes como la cantidad de plantas y sus combinaciones sea posible de realizar.
No existe ningún producto herbal igual a otro.
Tal vez dos productos puedan tener aplicaciones similares pero los efectos en el organismo animal, la respuesta del órgano diana y el desempeño final en los animales va a ser diferente en tanto y en cuanto sea variable la concentración de un determinado fitoquímico, la asociación y sinergia de varios fitoquímicos contenidos en la mezcla herbal para generar un mayor efecto y estimulación en el organismo animal.
Entre las características encontradas y comprobadas en los productos están:
Acción antioxidante (disminuye el estrés oxidativo)

Efecto anti-in amatorio
Intervienen activando o modulando mediadores químicos (IL) y receptores de actividades metabólicas, (PPAR´s ; PRR´s ; TPRV1)
Estabilizan la microbiota (Eubiosis)
Son productos de complejos toquímicos de múltiples funciones
Acción antimicrobiana, anticoccidial, antifúngica, antiviral (Son Selectivos)
No crean resistencia antimicrobiana
Sin período de retiro
Estimulan la respuesta inmune (Inmunomoduladores)
Mejoran la palatabilidad y/o mejoran el consumo del alimento Sinergia con Probióticos y otros Fitobióticos Se usan como mejoradores de desempeño (GDP y CA)
La actividad de los toquímicos ya está comprobada
Figura 1: Características encontradas y comprobadas en los productos herbales.
Los productos de herbales son tan diversos y diferentes como la cantidad de plantas y sus combinaciones sea posible de realizar.
Los terpenos funcionan como antioxidantes, estos protegen a los lípidos, a la sangre y a otros fluidos corporales contra el ataque de radicales libres, tales como algunas especies de oxígeno reactivo, grupos hidroxilos, peróxidos y radicales superóxidos.
Los terpenos más intensamente estudiados son los carotenoides y los limonoides.
Carotenoides: Esta subclase de terpenos se encuentra en los pigmentos de color amarillo intenso, naranja y rojo de algunos los vegetales. icono zanahoria
La familia de los carotenoides, incluyen dos tipos de moléculas: Carotenos Xantofilas
Los carotenos tienen un efecto favorable para el sistema inmunológico y protegen a la piel contra la radiación ultravioleta.
Las xantófilas son importantes porque parecen ejercer una función protectora en favor de la vitamina A, la vitamina E y otros carotenoides, en contra de los procesos de oxidación.
Saponinas: Son glucósidos de esteroides o de triterpenoides.
Por su capacidad para disminuir la tensión superficial de los líquidos contenidos en la dieta, facilitan la digestión y la absorción de nutrientes.
Por otro lado, una de las acciones más buscadas de las saponinas es su dinámico efecto sobre la integridad de las membranas de los protozoarios, demostrando tener un potente efecto anticoccidial.
Los fitoesteroles están presentes en la mayoría de las plantas. Tienen habilidad para bloquear la absorción del colesterol.
Fenoles: Los fenoles protegen a las plantas contra los daños oxidativos y llevan a cabo la misma función en el organismo animal.
La característica principal de los compuestos fenólicos es su habilidad como anti-inflamatorios, ya que bloquean la acción de enzimas específicas que causan inflamación.
Como antioxidantes, los fenoles también previenen la peroxidación de lípidos.
El grupo de los fenoles incluye a los flavonoides y sus subgrupos: Antocianidinas
Catequinas Ácidos gálicos
Isoflavonas
Estos compuestos favorecen también los efectos del ácido ascórbico (vitamina C). La actividad biológica de los flavonoides incluye: Acción contra alergias e inflamaciones
Atrapan radicales libres y hepatotoxinas


Evitan la aglomeración de plaquetas Actividad antimicrobiana y antiviral

Acción inhibitoria de ciertas enzimas
Las catequinas tienen propiedades antibacterianas
Los productos naturales son y serán cada vez más una alternativa de primera elección ante la necesidad de disponer de soluciones no antibióticas ni químicas sintéticas para el control de enfermedades.
Muchos de estos productos han demostrado ser efectivos para reducir la incidencia de diversas patologías y se ha comprobado sus efectos y beneficios mediante numerosos estudios científicos llevados a cabo por instituciones de renombre a nivel mundial.
La calidad, efectividad y eficiencia de los productos de origen natural y muy específicamente de los productos poliherbales va a depender de:

El tipo de compuestos fitoquímicos que contenga esa mezcla
La concentración
Y de la sinergia que se genere entre estos compuestos
Por último y he aquí el pilar fundamental de que realmente un producto natural funcione
de los procesos biotecnológicos para la elaboración de este tipo de productos, de la investigación y el desarrollo realizado al producto y, sobre todo, de la comprobación mediante pruebas in vivo realizadas en campo sobre el desempeño de sus productos y el comportamiento de los animales.
¿Los productos naturales en la Salud Intestinal, realmente funcionan?
DESCÁRGALO EN PDF

1Departamento de Ciência Animal, Universidade Federal do Rio Grande do Sul - UFRGS, Porto Alegre, RS, Brasil.
2Departamento de Ciência Animal, Universidade do Estado de Santa Catarina-UDESC, Chapecó, SC, Brasil
El uso de antibióticos como promotores de crecimiento en la producción animal ha sido objeto de numerosas discusiones. Esto ocurre en virtud de los relatos de resistencia bacteriana, el cual es un problema de salud pública mundial.
La Unión Europea prohibió la utilización de antimicrobianos promotores de crecimiento en 2006. Ya en Brasil, hubo una prohibición parcial de algunos fármacos en 2018 y 2020.
Incluso en este contexto, desde la década del ´70, los investigadores afirman que la carne de pollo es más propensa a la oxidación lipídica comparada con otras carnes (Gene e Pearson, 1979), y esto afecta su calidad nutricional y sensorial.
Buscando minimizar ese proceso, la industria de alimentación animal ha adicionado antioxidantes sintéticos en las raciones con el objetivo de generar un efecto nutracéutico y así prolongar la vida útil de la carne en góndola (Castañeda et al., 2005).
 Gabriela Miotto Galli1, Aleksandro Schafer da Silva2 e Ines Andretta1
Gabriela Miotto Galli1, Aleksandro Schafer da Silva2 e Ines Andretta1
Existen relatos sobre el efecto carcinogénico de los antioxidantes sintéticos en humanos, es por eso que desde la década del ´90 se están investigando acerca del uso de antioxidantes naturales en sustitución a los sintéticos (Chen et al., 1992).
Por lo tanto, con la prohibición de los promotores de crecimiento convencionales en algunos países, surgen productos comerciales en base a:
Esto tiene un efecto beneficioso en la reducción del ácido mirístico y palmítico, ya que son los responsables del aumento del colesterol LDL sérico, que está relacionado con las enfermedades cardiovasculares.
Los antioxidantes naturales son generalmente considerados como seguros, de esta forma, son una alternativa a los antioxidantes sintéticos (Hang et al., 2018) Daneshyar et al. (2011) al suministrar Curcuma en la dieta de pollos de engorde verificaron una menor cantidad de ácidos grasos saturados (AGS), principalmente ácido palmítico y C18:1 n-7 (ácidos grasos monoinsaturadosMUFA) en la carne del muslo, lo que puede ser explicado por la disminución de la síntesis de novo de los ácidos grasos en el hígado.
Hang et al. (2018) al agregar curcumina a la dieta de los pollos de engorde, observaron mayores proporciones de: ácido linoleico (C18: 2n-6) y ácidos grasos poliinsaturados totales omegaseis (PUFA), lo que resultó en una acumulación de ácido linoleico en la carne de pechuga. Además, no observaron cambios en los ácidos grasos omega-3 como: Eicosapentaenoico (EPA) y Docosahexaenoico (DHA), durante tres meses de almacenamiento, lo cual es beneficioso, ya que muestra un efecto protector de la curcumina sobre los ácidos grasos.
Hashemipour et al. (2013) al proporcionar timol y carvacrol en la dieta de pollos, encontraron una menor cantidad de SFA y un aumento de ácidos grasos poliinsaturados omega-6 en el muslo.
Ciftci et al. (2010) encontraron que el aceite de canela puede aumentar la proporción de PUFA y disminuir el contenido de SFA de la carne, debido a las propiedades hipolipidémicas del aceite de canela en las dietas.
La adición de monolaurato de glicerol (MLG) a la dieta de los pollos disminuyó la capacidad de retención de agua de la carne (FORTUOSO et al., 2019), así como estos pollos presentaron menor cantidad de lípidos en la carne (VALENTINI et al., 2019).
% de ácidos grasos en la carne
Por parte de las aves a lo largo del ciclo de producción también redujo los porcentajes de ácidos grasos saturados (AGS) en la carne de pechuga (P=0.001; Figura 1); pero por otro lado, incrementó el porcentaje de ácidos grasos poliinsaturados totales (P=0.001; GALLI et al., 2020b).

CN CP FI P<0.001
b b 0 5 10 15 20 25 30 35 40 45 AGPI
a a a b
AGS
Perfil de ácidos grasos total
Figura 1. Perfil de ácidos grasos saturados (SFA) y poliinsaturados (AGPI) en la carne de pollos de engorde suplementados con ración basal (CN), antibiótico y coccidiostático (CP) y fitogénico a base de timol, cinamaldehído y carvacrol (FIT). Letras iguales no difieren entre sí por la prueba de Tukey (P>0.05).
Este estudio también demostró que dosis de 200 y 300 mg/kg de FFM en la dieta es capaz de reducir la suma de ácidos grasos saturados y aumentar la suma de ácidos grasos poliinsaturados (Valentini et al., 2019), lo cual es un efecto deseable para los consumidores de carne.
El consumo de fitogénicos en base a:
Además, disminuyó los niveles de sustancias reactivas al ácido tiobarbitúrico (TBARS) y especies reactivas de oxígeno (ROS) y aumentó la enzima antioxidante superóxido dismutasa (SOD) en la carne de pechuga (GALLI et al., 2020a; Figura 3). Por lo tanto, esto demuestra que la adición de curcumina protegió a los ácidos grasos de la peroxidación lipídica.

La adición de 100 mg/kg de curcumina a la dieta de los pollos de engorde disminuyó los SFA (P=0,05) y aumentó los PUFA (P=0,02) en comparación con el grupo de promotores del crecimiento (Galli et al., 2020a; Figura 2).


Por lo tanto, se sabe que productos identificados como: Fitogénicos, Extractos de hierbas, Ácidos grasos y otros aditivos alteran el perfil de ácidos grasos de la carne, pero el mecanismo involucrado aún debe dilucidarse mejor.
CU CP
31,5a 29 30b 27,5b 0 5 10 15 20 25 30 35 AGPI

AGS
Perfil de ácidos grasos
Figura 2. Perfil de ácidos grasos saturados (SFA) y poliinsaturados (PUFA) en carne de pollos de engorde suplementados con antibióticos y coccidiostático (CP) y curcumina (CU). Letras iguales no difieren entre sí por la prueba de Tukey (P>0.05).

Sin embargo, se cree que el menor porcentaje de AGS en la carne puede deberse a una disminución en la síntesis de novo de ácidos grasos en el hígado y/o al aumento en la actividad de la enzima lipogénica ∆ 9 -desaturasa (stearoyl -CoA desaturasa), que convierte los ácidos grasos saturados en ácidos grasos monoinsaturados, una enzima conocida por modular la biosíntesis de ácidos grasos (Poureslami et al., 2010).
Como ya se mencionó, este hecho es beneficioso, ya que los AGS son los responsables del aumento del colesterol LDL sérico, es decir, transportan el colesterol desde el hígado para acumularlo en las venas, lo que provoca enfermedades cardiovasculares.
Cuando los aditivos alimentarios aumentan el porcentaje de ácidos grasos poliinsaturados (PUFA) totales en la carne, la explicación más probable es el aumento de la síntesis de las enzimas desaturasas A5, A6, (MENDONÇA et al., 2019) y A9 (Kumar et al., 2020) y elongasas.
ROS, TBARS
SOD, tióis
% de ácidos grasos en la carne de enzimas antioxidantes y del tiempo de vida útil
Figura 3. La adición de curcumina redujo la peroxidación lipídica de la carne y el daño causado por especies reactivas de oxígeno en el tejido muscular, lo que ha aumentado la vida útil y la calidad del producto final.
Los omegas tres y seis son beneficiosos para la salud humana, y los nutricionistas prescriben y fomentan el consumo de productos ricos en este tipo de ácidos grasos. A su vez, los AGPI participan en mecanismos reguladores del sistema cardiovascular e inmunológico (GRASHORN, 2007), además de estar relacionados con la síntesis de membranas celulares y con efectos positivos sobre la piel, el cabello y la visión.







Tierra de diatomeas purificada
Sepiolita Tierra de diatomeas purificada
Tierra de diatomeas purificada
Para más información, contáctenos en: info@naturaladditives.eu

Todas las especies animales (monogástricos, rumiantes y acuicultura). Presentaciones: Liquida, Soluble en agua o granulada. Dosificación según recomendación de Departamento Tecnico de ENA.
Tierra de diatomeas purificada
Sepiolita Tierra de diatomeas purificada
Bentonita (montmorillonita dioctahédrica). Paredes de levaduras (MOS+βglucanos). Tierra de diatomeas purificada.
Ácidos orgánicos
Ácidos orgánicos, 1-monoglicéridos, galactomananos
Distribuidor:
Flavonoides
Antiinflamatorio exclusivo COX 2. Reduce la respuesta inflamatoria y su coste metabólico . Reduce la síntesis y liberación de mediadores químicos de la inflamación. Los flavonoides presentes son potentes sustancias antioxidantes, protegiendo al animal del efecto de los radicales libres.
ENACOX2®
Flavonoides + terpenos
Reduce el estrés y su coste metabólico. Presenta afinidad por los receptores α-GABA de las neuronas, inhibiendo la transmisión nerviosa de las señales de ansiedad o excitación. Inhibe recaptación de GABA en el espacio sináptico.
Flavonoides + ácidos cafeoilquínicos
Detoxificación del organismo mediante la eliminación de toxinas a su paso por el hígado. Incremento de la producción y liberación de bilis . Estimulación de la movilización de las grasas, optimizando su digestión y absorción de vitaminas liposolubles.

Flavonoides + ácidos cafeoilquínicos
Reduccion de los síntomas en las mamitis clínicas y subclínicas periparto y mejora de la digestion de las grasas, en consecuencia hay un aumento de la produccion lactea y su % de grasa.
ENARELAX®
Flavonoides + terpenos + ácidos cafeoilquínicos
Mejoran la digestión de los nutrientes, aumentando su biodisponibildiad. A su vez, reduce la agresividad y el estrés de los animales, mejorando el bienestar animal. Optimiza el Índice de Conversión durante la etapa de cebo y mejora el transporte a matadero.
Flavonoides + ácidos cafeoilquínicos
Enfocado para ganado lechero, reduce la aparición de aflatoxina M1 en leche. Captación de micotoxinas en el tracto digestivo, evitando su absorción y detoxificación del organismo frente a toxinas (micotoxinas y sustancias indeseables) vía hígado.
Combinación de extractos de plantas estandarizada
Propiedades antimicrobianas y promotoras de la salud intestinal; especialmente eficaz frente a patógenos Gram+ y coccidia. No afectan a la flora intestinal endógena, y estimula la regeneración de la mucosa inrtestinal y la capacidad de absorción de nutrientes. Diseñado especialmente para la prevención de enteritis necrótica en avicultura.
Combinación de extractos de plantas estandarizada
Estrategia multidiana para la mejora de la salud intestinal. Actúa contra microrganismos patógenos de amplio espectro , Gram+ y Gram-. Mejora la función barrera intestinal y la morfología de las vellosidades intestinales. Diseñado especialmente para la prevención de colibacilosis en lechones destetados.
Aves, cerdos y rumiantes 500g-1000g/Tm de alimento
Aves, cerdos y rumiantes 250cc / 1000 litros de agua de bebida
Bovino: 50 gramos / vaca / día Ovino/caprino: 25 gramos / oveja /día
Para más información contáctenos en info@liptosa.com
Porcino: de 250 a 700cc/1000 litros de agua de bebida Aves: de 150 a 300cc/1000 litros de agua de bebida Hasta 7 días consecutivos
Monogástricos: uso en mezcladora de 1 a 3Kg/t de pienso
Porcino: uso continuado a 1kg/t de pienso. Uso en eventos a 2kg/t de pienso
Porcino: uso en mezcladora a 1kg/t de pienso de cerdas en periparto y lactantes. Uso a 1kg/t en lechones hasta 70 días de vida. Utilizar en el caso de riesgo de Estreptococias
Porcino: uso en mezcladora a 2kg/t de pienso. Utilizar en caso de riesgo durante los trastornos digestivos y en su convalecencia
Monogástricos: de 0,25 a 1L/MT de agua de bebida Ruminates: de 0,25 a 0,5L/Mt de agua de bebida
Componentes técnicos
Botánicos naturales definidos, aceites esenciales.
Ayuda a los animales a mantener un ambiente intestinal óptimo, minimizando las enteritis bacterianas secundarias como la enteritis necrótica y favoreciendo el control de la infección por coccidios.
Propilenglicol, glucosa monohidrato. Vitaminas A, D3, E y C. Otros.
Mezcla sinérgica de plantas tales como la menta, eucalipto y tomillo. Contiene una fuente de salicilatos.
Reducción de problemas respiratorios en entradas a cebo, reagrupamiento de animales, altas temperaturas, alta humedad, etc. Apoyo al tratamiento convencional de procesos respiratorios.
Componentes técnicos
Algas, productos derivados de la transformación de aromáticos y hierbas botánicas.
Ayuda a regular el proceso de rumia. En caso de presencia excesiva de proteínas o carbohidratos degradables en la dieta, permite su uso correcto y aumenta las proteínas y la energía disponible para el animal. Ayuda a una digestión eficiente de la fibra.
Monogliceridos y ácidos grasos
Aceites esenciales y extractos de plantas protegidos por componentes técnicos
Ayuda en control de enfermedades entéricas, mejorador de rendimientos zootécnicos.
Ácidos orgánicos
Aceites esenciales protegidos por componentes técnicos
Fitobiótico, mejorador de rendimientos zootécnicos.
Minerales quelados
Aceites esenciales y extractos de plantas protegidos por componentes técnicos
Ayuda en control de ileítis y disentería. Efecto probiótico y astringente.
Monogliceridos y ácidos grasos
Aceites esenciales y extractos de plantas protegidos por componentes técnicos
Minerales quelados
Aceites esenciales y extractos de plantas protegidos por componentes técnicos
Ácidos grasos, extractos de levadura
Extractos vegetales
Ayuda en control de Estreptococias.
Sustitución de Óxido de Zinc y de colistina, estabilización de digestion fisiológica.
Solución integral a los daños en los principales órganos y funciones metabólicas producidos por micotoxinas, enfermedades y problemas nutricionales.
Hygen Pro
Hygen Pro Law
Hygen Pro Strept
Hygen Pro Complet
Liptosafe L
ver ficha
PAÍSES EN LATINOAMÉRICA DONDE EL PRODUCTO ESTÁ DISPONIBLE
ESPECIES DE DESTINO Y DOSIFICACIÓN
COMPONENTES SECUNDARIOS (NO FITOGÉNICOS)
COMPONENTES ACTIVOS FITOGÉNICOS
México, Guatemala, Honduras, El Salvador, Nicaragua, Costa Rica, Rep Dominicana, Colombia, Ecuador, Perú, Chile, Bolivia.
Aves de corral/cerdos: agregar y mezclar 0.75-2.0 L/ 1000 l de agua de bebida y suministrar por al menos durante 5 días consecutivos Lechones destetados: Suministrar 3-5 ml por animal por día por al menos durante 5 días consecutivos
Substancias Lipotropicas (vitaminas y aditivos)
México, Guatemala, Honduras, El Salvador, Nicaragua, Costa Rica, Rep Dominicana, Colombia, Ecuador, Perú, Chile, Bolivia.
En caso de riesgo, prevención y tratamiento de los trastornos (diarrea) y su convalecencia Lechones: Administración oral 2 ml (1 dosis) Corderos y cabritos: Administración oral 4 ml (2 dosis) La aplicación puede repetirse si fuese necesario
México, Guatemala, Honduras, El Salvador, Nicaragua, Costa Rica, Rep Dominicana, Colombia, Ecuador, Perú, Chile, Bolivia.
Pollitos: 100 ml Miarom L por cada 1000 l de agua de bebida Avicultura: 100250 ml Miarom L por cada 1000 l de agua de bebida Aplicación en espray: 1,0 l por cada 100 l de agua a esprayar
México, Guatemala, Honduras, El Salvador, Nicaragua, Costa Rica, Rep Dominicana, Colombia, Ecuador, Perú, Chile, Bolivia.
Pollitos: 150-250 g por cada tn de alimento compuesto Avicultura: 250-350 g por cada tn de alimento compuesto Cerdo: 300-400 g per por cada tn de alimento compuesto Lechones: 200-350 g por cada tn de alimento compuesto Cerdas: 300-500 g por cada tn de alimento compuesto Terneros de engorde: 3-5 g per por cada tn de alimento compuesto Terneros: 1000 g por tonelada de lactoreemplazante (con aproximadamente 1 kg de consumo de lactoreemplazante por animal y día)
ACCIÓN
Extractos de Alcachofa y Silimarina
Electrolitos
Taninos de castaña
Protección hepática
Control de diarreas neonatales en lechones
NOMBRE PRODUCTO
Livervital

MiaFirstAid L

Mezcla de aceites esenciales
Estimulo del apetito, control de desafios a nivel respiratorios y manejo de situacions de estrés térmico. Mejora general del estado de salud, reduciendo el uso de antibióticos.
Mezcla de aceites esenciales
Estimulo del apetito, control de desafios a nivel respiratorios y manejo de situacions de estrés térmico. Mejora general del estado de salud, reduciendo el uso de antibióticos.
Miarom L
Miarom P
Argentina, Bolivia, Chile, Costa Rica, Guatemala, Honduras, Panama, Ecuador, México, Peru, Colombia, Republica Dominicana, Paraguay
Argentina, Bolivia, Chile, Costa Rica, Guatemala, Honduras, Panama, Ecuador, México, Peru, Colombia, Republica Dominicana, Paraguay
Todas las especies: 100-350g/tn alimento balanceado. Consulte con su técnico de Nuproxa para establecer una dosificación personalizada.
Todas las especies: 100-350g/tn alimento balanceado. Consulte con su técnico de Nuproxa para establecer una dosificación personalizada.
Argentina, Costa Rica, Ecuador, México, Peru
Argentina, Costa Rica, Ecuador, México, Peru
Todas las especies: reemplazo del 50% de metionina sintética. Consulte con su técnico de Nuproxa para establecer una dosificación personalizada.
Todas las especies: reemplazo del 50% de metionina sintética. Consulte con su técnico de Nuproxa para establecer una dosificación personalizada.
Argentina, Bolivia, Chile, Costa Rica, Guatemala, Honduras, El Salvador, Panama, Ecuador, México, Peru, Colombia, Republica Dominicana, Paraguay
Argentina, Bolivia, Chile, Costa Rica, Guatemala, Honduras, El Salvador, Panama, Ecuador, México, Peru, Colombia, Republica Dominicana, Paraguay
Todas las especies: 500g/tn alimento balanceado. Consulte con su técnico de Nuproxa para establecer una dosificación personalizada.
Todas las especies: 500g/tn alimento balanceado. Consulte con su técnico de Nuproxa para establecer una dosificación personalizada.
Argentina, Bolivia, Chile, Costa Rica, Guatemala, Honduras, El Salvador, Panama, Ecuador, México, Peru, Colombia, Republica Dominicana, Paraguay
Argentina, Bolivia, Chile, Costa Rica, Guatemala, Honduras, El Salvador, Panama, Ecuador, México, Peru, Colombia, Republica Dominicana, Paraguay
Todas las especies: 250g/tn alimento balanceado. Consulte con su técnico de Nuproxa para establecer una dosificación personalizada.
Todas las especies: 250g/tn alimento balanceado. Consulte con su técnico de Nuproxa para establecer una dosificación personalizada.
Chile, Argentina, Bolivia, Costa Rica, Ecuador, México, Colombia, Paraguay
Chile, Argentina, Bolivia, Costa Rica, Ecuador, México, Colombia, Paraguay
Consulte con su técnico de Nuproxa para establecer una dosificación personalizada.
Consulte con su técnico de Nuproxa para establecer una dosificación personalizada.
Chile, Argentina, El Salvador, Ecuador, Peru
Chile, Argentina, El Salvador, Ecuador, Peru
Todas las especies: 100-350g/tn alimento balanceado. Consulte con su técnico de Nuproxa para establecer una dosificación personalizada.
Todas las especies: 100-350g/tn alimento balanceado. Consulte con su técnico de Nuproxa para establecer una dosificación personalizada.
Chile, Argentina, Bolivia, Costa Rica, Honduras, El Salvador, Panama, Ecuador, México, Colombia, Paraguay
Chile, Argentina, Bolivia, Costa Rica, Honduras, El Salvador, Panama, Ecuador, México, Colombia, Paraguay
Todas las especies: 100-200g/tn alimento balanceado. Consulte con su técnico de Nuproxa para establecer una dosificación personalizada.
Todas las especies: 100-200g/tn alimento balanceado. Consulte con su técnico de Nuproxa para establecer una dosificación personalizada.
Chile, Argentina, Bolivia, Costa Rica, Guatemala, Honduras, El Salvador, Panama, Ecuador, Peru, Colombia, Republica Dominicana, Paraguay
Chile, Argentina, Bolivia, Costa Rica, Guatemala, Honduras, El Salvador, Panama, Ecuador, Peru, Colombia, Republica Dominicana, Paraguay
Consulte con su técnico de Nuproxa para establecer una dosificación personalizada.
Consulte con su técnico de Nuproxa para establecer una dosificación personalizada.
Conjugados de fosfatidicolina entre otros
Conjugados de fosfatidicolina entre otros
Aditivo modulador metabólico natural, que mejora el desempeño y la calidad de canal a través de la activación de los receptores PPARα. Participación en procesos metabólicos a nivel del uso de la energía de la dieta. Su contenido en fosfatidilcolina tambien contribuye a sustituir el 100% del cloruro de colina de la dieta.
Aditivo modulador metabólico natural, que mejora el desempeño y la calidad de canal a través de la activación de los receptores PPARα. Participación en procesos metabólicos a nivel del uso de la energía de la dieta. Su contenido en fosfatidilcolina tambien contribuye a sustituir el 100% del cloruro de colina de la dieta.
Trigonelline y L-metionina
Trigonelline y L-metionina
Aditivo natural que mejora la eficiencia nutricional a través de la optimizacion del metabolismo de la metionina. Sustituye parcialmente a la Metionina sintética reduciendo el coste de formulación.
Aditivo natural que mejora la eficiencia nutricional a través de la optimizacion del metabolismo de la metionina. Sustituye parcialmente a la Metionina sintética reduciendo el coste de formulación.
BioCholine®
BioCholine®
Aditivo natural que mejora del rendimiento productivo de los animales a través de la modulación de la microbiota intestinal, reducción de la inflamación crónica y del estrés oxidativo. Además, contribuye en gran medida al control de coccidias. Taninos, saponinas y polifenoles entre otros
Aditivo natural que mejora del rendimiento productivo de los animales a través de la modulación de la microbiota intestinal, reducción de la inflamación crónica y del estrés oxidativo. Además, contribuye en gran medida al control de coccidias. Taninos, saponinas y polifenoles entre otros
Terpenoides y flavonoides
Terpenoides y flavonoides
Aditivo natural que mejora los rendimientos productivos de los animales por su efecto protector de la función hepática gracias a su actividad antioxidante, detoxificante y estimulante de la secrección biliar.
Aditivo natural que mejora los rendimientos productivos de los animales por su efecto protector de la función hepática gracias a su actividad antioxidante, detoxificante y estimulante de la secrección biliar.
LivoLiv®
Polifenoles
Polifenoles
Antioxidante metabólico natural para la protección del estrés oxidativo de los animales contribuyendo para la mejora de parámetros productivos, reproductivos y de calidad de carne. Sustituto parcial de la Vitamina E sintética (en una proporción de 1g del producto para cada 11g de vitamina E pura) reduciendo el coste de formulación.
Antioxidante metabólico natural para la protección del estrés oxidativo de los animales contribuyendo para la mejora de parámetros productivos, reproductivos y de calidad de carne. Sustituto parcial de la Vitamina E sintética (en una proporción de 1g del producto para cada 11g de vitamina E pura) reduciendo el coste de formulación.
Tocoferoles
Tocoferoles
Producto natural que contiene diferentes isómeros de la Vitamina E altamente biodisponibles, con rápida absorción y lenta excreción.
Producto natural que contiene diferentes isómeros de la Vitamina E altamente biodisponibles, con rápida absorción y lenta excreción.
NuxaFen®
Polifenoles, ácido gálico y sus derivados
Polifenoles, ácido gálico y sus derivados
Sustituto herbal de la Vitamina C, utilizado para frenar el estrés oxidativo y el estrés por calor. Es estable en medio acuoso, a temperatura ambiente y a temperaturas de granulación.
Sustituto herbal de la Vitamina C, utilizado para frenar el estrés oxidativo y el estrés por calor. Es estable en medio acuoso, a temperatura ambiente y a temperaturas de granulación.
Herbal-E®
1,25(OH)2D3
1,25(OH)2D3
Único aditivo 100% natural fuente del metabolitito activo de la Vitamina D 1,25 (OH)2D3.
Único aditivo 100% natural fuente del metabolitito activo de la Vitamina D 1,25 (OH)2D3.
Herbal-E®
C-Power®
C-Power®
Panbonis®
Panbonis®
PAÍSES EN LATINOAMÉRICA DONDE EL PRODUCTO ESTÁ DISPONIBLE
ESPECIES DE DESTINO Y DOSIFICACIÓN
COMPONENTES SECUNDARIOS (NO FITOGÉNICOS)
COMPONENTES ACTIVOS FITOGÉNICOS
México, Argentina, Brasil, Ecuador
Pollos: 150250 ml/ 1,000 L de agua de bebida Cerdos: 250350 ml/ 1,000 L de agua de bebida Terneros lactantes: 2 ml/ día Peces marinos y de agua dulce: 5001000 ml/ 1,000 L agua Crustáceos: 1000 -2000 ml/ 1000 L agua
Aceite de Orégano, Aceite de Ajo
ACCIÓN
Antimicrobial, Bactericida, Antioxidante
NOMBRE PRODUCTO
COXSAN
México, Brasil, Chile, Ecuador
Pollos y Cerdos: 200250 ml/ 1,000 L de agua de bebida
México
México, Argentina, Chile, Colombia,
México, Argentina, Chile, Colombia
México, Argentina, Colombia,
México, Argentina, Uruguay, Ecuador, Chile
México
México
Pollos, cerdos y rumiantes: 250350 g / t de alimento ver ficha
Pollos, cerdos y rumiantes
Terneros de engorde: 0,8 g/ animal / día
Vaca lechera: 0,5 g/ animal/ día
Pollos: 100200 g/ t de alimento
Pollos: 250500 g/ t de pienso Cerdos: 350500 g/ t de alimento Terneros: 250 g/ t de alimimento Peces marinos y de agua dulce: 500 g1000 g/ t de alimento Crustáceos: 1-2 kg / t de alimento
50100 g/ t de alimento
Monobutirina
Mentol, Eucalyptus Globulus
Antimicrobial, Mucolítico, Expectorante
Cinamaldehido, Carvacrol
Eugenol, Cinamaldehido, Capsicum
Eugenol, Cinamaldehido, Anetol
Cúrcuma, Piperina, Cinamaldehido, Oleoresina de Capsicum
Aceite de Orégano, Aceite de Ajo
Oleoresina de Capsicum
Mentol, Eucalyptus Globulus, Gaultheria
LICOROL
Bactericida
Antimicrobial, Antioxidante, mejorador del rumen
PHYTOBUTYRIN

PHYTMAX® BEEF CATTLE
Antimicrobial, Antioxidante, mejorador del rumen
PHYTMAX® DAIRY COW
Antimicrobial, Inmunoestimulante
Amtimicrobial, Bactericida, Antioxidante
Antimicrobial, Antioxidante

Antimicrobial, Mucolítico, Expectorante
PHYTMAX® COX
COXSAN PREMIX
PHYTMAX® CAPSICUM ENCAPS
PAÍSES EN LATINOAMÉRICA DONDE EL PRODUCTO ESTÁ DISPONIBLE
ESPECIES DE DESTINO Y DOSIFICACIÓN
COMPONENTES SECUNDARIOS (NO FITOGÉNICOS)
COMPONENTES ACTIVOS FITOGÉNICOS
Latinoamerica
Latinoamerica
ACCIÓN
Aves, 0,5 a 1 kg/t
NOMBRE PRODUCTO
Humulus lupulus, Cichorium intybus, Triticum spp
Aves 0,250 a 1 kg/t
Modulador de la microbiota intestinal
Herbanoplex® CP
Silybum marianum
Protector de tejidos de alta demanda metabólica
Heptarine® S


Di


RECOMENDACIONES DE USO
Ayuda al sistema digestivo de los animales monogástricos mediante la rotura de los pentosanos (principalmente arabinoxilanos) y otras fracciones fibrosas presentes en los granos de los cereales
LATAM
Hidroliza el fitato de los ingredientes vegetales liberando el fósforo ligado al fitato y reduciendo los efectos negativos del fitato
ESPECIES DE DESTINO
Avicultura y porcino
DOSIS
50-150 g/T
COMPOSICIÓN
Avicultura y porcino
50-500 g/T
a Endo1,4-beta-xilanasa: 160.000 BXU/g
ACTIVIDAD ENZIMÁTICA
a 6 fitasa mejorada: 5.000 FTU/g
Xilanasa
PRODUCTO
LATAM
Recomendado en sistemas de producción intensivos. La incorporación de RUMINO-ZYME al alimento mejora la performance productiva de rumiantes lecheros y de engorde, incrementando la producción de leche y la ganancia de peso respectivamente.
Econase XT
Actualización Tablas Enzimas
Fitasa
Quantum Blue
Rumiantes
1 Kg por Tn de alimento
Producto seco de fermentación de Aspergillus oryzae , 5 g Marlo de maíz molido c.s.p, 100g Xilanasas (500 UI/G) Aspergillus oryzae 2x10⁴ UFC/g
Producto enzimático con actividad xilanasa, efectiva para la degradación de material fibroso vegetal en alimentos para bovinos lecheros y de engorde. Mejora la digestibilidad de la materia seca y de la fibra detergente neutra.
PAÍSES EN DISTRIBUCIÓN
ESPECIES DE DESTINO RECOMENDACIONES DE USO
DOSIS
100g/T
50g/T
LATAM
Incorporación en mezclas de alimentos
Todas las especies animales
COMPOSICIÓN
a Complejo termoestable multienzimático concentrado compuesto por xilanasa, β-glucanasa, celulasa, arabinofuranosidasa y 1.000FTU de fitasa
ACTIVIDAD ENZIMÁTICA
Endo-1,4-xilanasa ≥12.500 UV/g Endo-1,3(4)-β-glucanase ≥8.600 UV/g 6-fitasa ≥10.000FTU/g Arabinofuranosidasa ≥46.000 ABF/g Endo-1,4-β-glucanasa (celulasa) ≥1.200 unidades DNS/g
PRODUCTO
Rovabio Advance Phy
a Complejo multi-enzimático concentrado compuesto por xilanasa, β-glucanasa, celulasa, arabinofuranosidasa y 500 FTU de fitasa.
Endo-1,4-xilanasa ≥25.000 UV/g Endo-1,3(4)-β-glucanase ≥17.200 UV/g 6-fitasa ≥10.000FTU/g Arabinofuranosidasa ≥92.000 ABF/g Endo-1,4-β-glucanasa (celulasa) ≥2.400 unidades DNS/g
Rovabio Max Advance
50g/T
a Complejo multi-enzimático concentrado compuesto por xilanasa, β-glucanasa, celulasa, arabinofuranosidasa termoestable.
Endo-1,4-xilanasa ≥25.000 UV/g Endo-1,3(4)-β-glucanase ≥17.200 UV/g Arabinofuranosidasa ≥92.000 ABF/g Endo-1,4-β-glucanasa (celulasa) ≥2.400 unidades DNS/g
Rovabio Advance TFlex
50g/T
a Complejo multi-enzimático concentrado compuesto por xilanasa, β-glucanasa, celulasa, arabinofuranosidasa. ver ficha
Rovabio Advance P
TechnoSpore®
TechnoSpore® Bacillus coagulans DSM 32016. Seleccionado especialmente para apoyar la salud y el rendimiento en los animales monogástricos.




TechnoSpore® Bacillus coagulans DSM 32016. Seleccionado especialmente para apoyar la salud y el rendimiento en los animales monogástricos. TechnoSpore® TechnoSpore® condiciones ambientales. Contáctenos : sac@biochem.net






Brasil se destaca como productor mundial de carne de pollo; en 2020, la producción fue de 13.845 millones de toneladas (ABPA, 2021).
A pesar de que el sistema de producción intensivo favorece la optimización y la productividad; también se observa que facilita la diseminación de patógenos y desafíos sanitarios.
En este escenario, el uso de antimicrobianos permite el mantenimiento de la salud de los lotes, sin embargo, el uso excesivo o inadecuado favorece la selección de bacterias resistentes (OIE, 2020).
Ante esto, el sector ha sido apuntado como uno de los responsables de la resistencia a los antimicrobianos (COLLIGNON; MCEWEN, 2019) y, con ello, se incrementaron las preocupaciones y exigencias tanto del gobierno como de los mercados de consumo.
Estudios demostraron un alto perfil de resistencia antimicrobiana en aislamientos de E. coli provenientes de productos de origen avícola (ROTH et al., 2019).
Koga et al. (2019) observaron que 79% de las muestras de E. coli aisladas de carcasas de pollo, comercializadas en la región norte de Paraná, presentaban un perfil multirresistente a los antimicrobianos. Kanabata et al. (2019) detectaron 77,3% de múltiple resistencia a fármacos en aislamientos de E. coli, provenientes de lesiones de celulitis aviar.

Los probióticos están siendo estudiados y empleados como forma de control de patógenos.
Estos productos se definen como microorganismos vivos que confieren beneficios para la salud del hospedador cuando se administran de forma adecuada (FAO/OMS, 2002), ya que presentan diferentes mecanismos de acción, que van desde la exclusión competitiva a la producción de metabolitos con acción antimicrobiana (CHUGH, KAMALELDIN, 2020).
Los Lactobacillus spp. son bacterias ácido lácticas que presentan acción probiótica y son reconocidas como GRAS -“Generally Regarded As Safe” (ZAWISTOWSKA-ROJEK1 y TYSKI1, 2018).

Estos microorganismos y sus bacteriocinas pueden ser alternativas al uso de antimicrobianos en producción animal.

En base a lo expuesto, este estudio tiene como objetivo evaluar el efecto antagonista de cepas de Lactobacillus spp. provenientes del producto comercial (FloraMax-B11TM) frente a diferentes aislamientos de Escherichia coli de origen avícola.
Fueron aisladas bacterias Escherichia coli (n=35) de muestras de hisopos de arrastre, hisopos de cloaca y de la superficie de Alphitobius diaperinus, presentes en granjas de pollos de engorde del norte de Paraná. Para ello, se utilizó la metodología ISO 16654 para detección de E.coli.
Las cepas de Lactobacillus spp. utilizadas en este estudio son derivadas del producto comercial FloraMax-B11™.
El antagonismo entre las cepas probióticas y las E. coli aisladas fue evaluado por la técnica de Spot on the Lawn (JOTHI & SHANKAR, 2012).
En primer lugar, se realizó el cultivo de Lactobacillus spp. en un caldo MRS incubado a 37ºC por 24 horas, en condiciones de microaerofilia.
Posteriormente, el inóculo de la cepa probiótica fue colocado en agar MRS e incubado en las condiciones descritas. Al mismo tiempo, los aislamientos de E. coli fueron incubados en un caldo BHI a 37ºC por 24 horas.
| Evaluación de la actividad antagonista de FloraMax-B11™ frente a aislamientos de Escherichia coli (APECs) multirresistentes a antimicrobianos
Luego del periodo de incubación de las muestras de Lactobacillus spp y E. coli, el cultivo de E. coli, con 109 UFC/ml, fue inoculado en una proporción 1:100 en BHI semi sólido y vertido sobre la placa MRS que contenían Lactobacillus spp.

(++) 6 a 11 mm; (++++) por encima de 18mm
de
Número de muestras
Fue posible observar que los Lactobacillus spp. fueron capaces de formar halos de inhibición en el 100% de las muestras de E. coli analizadas, con predominio de halos mayores que 5 mm hasta 18 mm (Figura 1).
Figura 1. Halo de inhibición (mm) producido por Lactobacillus spp. frente a E. coli. Fuente: Laboratório de Medicina Aviária - LMA - UEL
En el 60 % (21/35) de las muestras, los halos formados midieron de 6 a 11 mm, corroborando el estudio de Jothi et al. (2012), quienes obtuvieron halos con medidas entre 7 a 9 mm con Lactobacillus spp. frente a E. coli. (Figura 2).
60% 50% 40% 30% 20% 0% 2,86% ++ +++ + 0,5mm = +, > 5 < 12mm = ++, 12-18mm = +++
60% 37,14%
Figura 2. Distribución de halos de inhibición (mm) producido por Lactobacillus spp. frente a E. coli.
GARRIGA et al. (1998) realizaron un estudio evaluando la eficacia de diferentes cepas de Lactobacillus spp. frente a E. coli CTC 1028 y el 100 % de las cepas testadas presentaron el mismo resultado, dos cruces de inhibición, mientras que en el presente estudio se observaron resultados más heterogéneos, siendo:


El 60% (22/35) con dos cruces de inhibición
El 37,14% (13/35) con tres cruces
Y apenas el 2,86% con una cruz (1/35)
La acción inhibitoria de Lactobacillus spp. probablemente se deba a la disminución del pH y a la acción del ácido láctico, así como también a la producción de bacteriocinas, similar a lo observado por PEREIRA y GOMEZ (2007).
Bibliografía disponible en la versión online
Fue posible observar la acción inhibidora de Lactobacillus spp. provenientes de FloraMaxB11TM sobre aislamientos de E. coli multirresistentes a los antimicrobianos, indicando ser una forma posible de control de este patógeno.
Evaluación de la actividad antagonista de FloraMax-B11™ frente a aislamientos de Escherichia coli (APECs) multirresistentes a antimicrobianos
DESCÁRGALO EN PDF
|
Evaluación de la actividad antagonista de FloraMax-B11™ frente a aislamientos de Escherichia coli (APECs) multirresistentes a antimicrobianos


Iglesias BF1, Charrière MV1, Gaggiotti M2, Fain Binda V1, Chale J1, Prieto GM3.
1Sección Avicultura, INTA-EEA Pergamino;
2Laboratorio de Forrajes, INTA-EEA Rafaela;
3AER Arroyo Seco, INTA-EEA Oliveros.
La alimentación impacta en un 55% en el total de los costos de producción de las aves (Nahara, 2018). En la actualidad, este sector se enfrenta a un nuevo y desafiante escenario: el aumento del precio de los ingredientes tradicionales.

A nivel internacional, el maíz y la soja mostraron un aumento en el precio del 88 y 57% en los últimos 24 meses, respectivamente (IndexMundi, 2022).
Este aumento de precios motiva la necesidad de buscar ingredientes alternativos en pos de abaratar costos.
La arveja, guisante o chícharo (Pisum sativum) se presenta como una alternativa viable en nuestro país. El INASE de Argentina (Instituto Nacional de Semillas, 2022) cuenta con más de 87 variedades registradas que pueden ser de grano verde o amarillo.
Siendo los cultivares más sembrados son la Viper para arveja verde y la Yams para arveja amarilla (Prieto, 2009).
El grano de arveja es un ingrediente con buen potencial para la alimentación animal, se caracteriza por tener:


Alto contenido de proteína bruta (20-26%)
Buena palatabilidad
Bajo contenido de factores antinutricionales (Galméus, 2012; de Blas et al., 2019).
Su proteína, constituida por albúminas y globulinas, es deficitaria en aminoácidos azufrados y triptófano, pero rica en lisina
La digestibilidad de la proteína y aminoácidos es similar a la de la harina de soja. Tiene bajo nivel de grasa y un alto contenido de almidón (42-51%) (de Blas et al., 2019).
En términos generales, las leguminosas se caracterizan por la presencia de factores antinutricionales, como:
Inhibidores de tripsina
Fitohemaglutininas
Glucósidos cianógenos
Saponinas
Alcaloides
Aminoácidos no proteicos (Cubero & Moreno, 1983; Monari, 1996), que afectan negativamente el desempeño productivo de las aves (Iglesias & Azcona, 2012).
La mayoría de estos factores antinutricionales pueden ser desactivados por calor (extrusión, vapor y aire caliente) y existen evidencias de que un tratamiento térmico, como la extrusión sobre la harina de arveja mejora la digestibilidad del almidón en truchas (Burel et al., 2000).
A nivel de laboratorio se podría lograr un efecto similar empleando microondas (Chale et al., 2017).
Caracterizar nutricionalmente dos cultivares de arveja, uno verde y otro amarillo.
Evaluar el efecto del desactivado por microondas
También se determinó fibra detergente neutro (FDN) a través del método de Goering y Van Soest (1970), con agregado de α-amilasa, y fibra detergente ácido (FDA) acorde a la metodología de Van Soest (1963).
Además, se midió la actividad ureásica e inhibidores de tripsina.
Para complementar la caracterización química, se realizó la determinación de energía metabolizable verdadera (EMV) (Sibbald, 1976), y su corrección por nitrógeno (EMVn), empleando 6 gallos por muestra.
Se tomaron muestras de arvejas de los cultivares Viper y Yams, verde y amarilla respectivamente, de las campañas 2019 y 2020 cultivadas en Argentina.
Sobre las que se le determinó:
Materia seca
Proteína bruta (PB) mediante el método Kjeldahl
Extracto etéreo (EE) extraído con hexano
Fibra cruda (FC)
Cenizas
Almidón
Para evaluar el efecto de desactivado por microondas se colocó una muestra de 200 g de arveja cruda en forma de monocapa en el plato del microondas de 900 Watts de potencia y se cocinó al 70% de potencia a distintos tiempos (0, 3, 5, 6, 7 y 9 min), en 3 tandas (repeticiones) (Chale et al., 2017).

Se empleó un diseño completamente aleatorizado con 6 tratamientos y 3 repeticiones cada uno.
de arveja para la alimentación de aves y efecto del desactivado con

Los análisis que se realizaron fueron:
Materia seca
Proteína bruta mediante el método de Kjedahl
Actividad ureásica (AU)
Solubilidad de proteínas (SP)

Nitrógeno insoluble en detergente ácido (NIDA)
Energía metabolizable verdadera por la técnica de Sibbald (1976). Donde se emplearon 3 gallos por repetición.
Los datos fueron sometidos a análisis de la varianza (ANOVA), cuando el grado de significancia resultó menor al 5%, la comparación de medias se realizó por la prueba de diferencias mínimas significativas (Di Rienzo et al., 2020).
En el Cuadro 1 se muestran los resultados de composición de las arvejas Viper y Yams de las campañas 2019 y 2020 y los valores para arveja de las tablas FEDNA (de Blas et al., 2019).

Parámetro (%) 2019 2020 2019 2020 2018
Materia seca 90,88 92,47 90,12 88,81 88,10
Proteína bruta 19,15 17,18 19,32 19,54 20,58
Extracto etéreo 0,84 1,20 0,86 1,17 1,40
Cenizas 3,02 2,58 2,77 2,70 2,80
Fibra cruda 3,83 5,16 4,20 8,98 5,99
FDN 23,83 17,27 13,98 16,75 12,09
FDA 16,90 7,68 6,66 8,52 7,39
Almidón 40,22 43,65 45,32 44,70 42,45
Calcio 0,20 0,49 0,12 0,53 0,08
Fósforo 0,13 0,08 0,13 0,07 0,40
Activ. ureásica (▲pH) 0,04 0,07 0,05 0,07
Inhib. tripsina (UTI/mg) 1,32 0,79 1,10 1,76
EB (kcal/kg) 3883 3885 3884 3867
EMV (kcal/kg) 2774 2816 2670 2821
EMV / EB 74,1 73,0 69,5 73,0
EMVn (kcal/kg) 2639 2655 2543 2548
EMVn / EB 68,0 68,9 66,2 65,9
Datos estandarizados al 88% de MS, excepto materia seca. EB: Energía bruta; EMV: Energía metabolizable verdadera; EMVn: Energía metabolizable verdadera corregida por nitrógeno. *Fuente: (de Blas et al., 2019)
Si bien no se ha realizado un análisis estadístico debido a las pocas muestras analizadas, no se han encontrado grandes diferencias entre cultivares y entre campañas.
Los parámetros que más se vieron afectados por el cultivar, y también por la campaña, fueron los relacionados con fibra, ya sea FC, FDN y FDA; y solo entre campañas se observaron diferencias importantes en EE, pero esto no repercutió en los valores de EB.
Al comparar los cultivares locales, con los tabulados por FEDNA (de Blas et al., 2019), los parámetros que más difirieron fueron los mismos, FC, FDN, FDA y EE, sin embargo, la arveja amarilla Yams fue más parecida a la presentada en las tablas que la verde Viper.
Tiempo de cocción (min)
En el Cuadro 2 se muestran los resultados del desactivado de arveja empleando microondas.
Cuadro 2. Efecto del desactivado de arveja con microondas sobre parámetros químicos.
MS PB*
*Datos estandarizados al 88% de MS.
MS: Materia seca; PB: Proteína bruta;
AU: Actividad ureásica; PS: Proteína soluble en KOH 0,2%; NIDA: Nitrógeno insoluble en detergente ácido. Medias con diferente superíndice, difieren estadísticamente (p≤0,05).
%
pH
% 0 88,74f 24,05 0,06a 71,77a 2,19b 3 90,62e 22,56 0,04b 71,77a 3,74b 5 92,54d 23,67 0,03bc 55,62b 3,23b 6 94,14c 25,03 0,02cd 43,80c 3,39b 7 95,01b 25,10 0,02cd 35,94d 4,93b 9 96,39a 24,72 0,01d 24,01e 12,76a
Probabilidad <0,01 0,16 <0,01 <0,01 <0,01
Efecto lineal <0,01 0,49 <0,01 <0,01 <0,01 Efecto cuadrát. 0,31 0,33 0,24 <0,01 <0,01
CV (%)
0,4 3,9 26,8 8,2 38,0
Al incrementarse el tiempo de cocción, y como era de esperar, la humedad de la muestra disminuyó, por lo que se incrementó el porcentaje de MS en forma lineal (p≤0,05). Mientras que, el porcentaje de proteína estandarizado al 88% de MS no se vio afectado por el tiempo de cocción (p>0,05).
Con actividad ureásica se encontró un efecto lineal debida al tiempo de cocción (p≤0,05), al igual que en PS en KOH.
Sin embargo, en este último parámetro también se encontró un efecto cuadrático (p≤0,05), posiblemente debido a la falta de diferencias entre 0 y 3 min de cocción (p>0.05), mientras que, con 5 min, este valor disminuyó significativamente (p≤0,05), y así sucesivamente con cada tiempo evaluado (6, 7 y 9 min).
En el caso de NIDA, la respuesta fue cuadrática (p≤0,05), pero este parámetro fue menos sensible, dado que recién se encontró una diferencia significativa luego de 9 min de cocción (p≤0,05).
En el Cuadro 3 se pueden hallar los valores energéticos en función de los diferentes tiempos de cocción.
Cuadro 3. Efecto del desactivado de arveja con microondas sobre parámetros energéticos.
EMV EMV / EB kcal/kg %
2738cd 70,63b 3 2793cd 72,06b 5 2942a 75,54a 6 2901ab 74,12ab 7 2812bc 71,93bc 9 2702d 68,69d
0
Probabilidad <0,01 <0,01 Efecto lineal 0,85 0,53 Efecto cuadrát. <0,01 <0,01 CV (%) 2,2 2,0
Datos estandarizados al 88% de MS. EMV: Energía metabolizable verdadera; EB: Energía bruta. 9Medias con diferente superíndice, difieren estadísticametne (p≤0,05).
de arveja para la alimentación de aves y efecto del desactivado con microondas
En cuanto al análisis energético, a medida que se incrementó el tiempo de cocción, aumentó significativamente la EMV de la muestra (p≤0,05), hasta llegar a un máximo a los 5 min de cocción (+204 kcal/ kg respecto del crudo), al igual que lo que ocurre con la utilización de la EB (EMV/EB), observándose claramente una respuesta cuadrática en estos parámetros (p≤0,05, Cuadro 3 y Gráfico 1).
Una situación similar se observó con soja, pero el tiempo necesario para lograr un desactivado óptimo con microondas fue de 6 min (Chale et al., 2017).
Se observaron mejoras en los parámetros energéticos (+204 kcal/ kg en EMV y +4,9 puntos porcentuales en EMV/EB, luego de 5 min de cocción).

Éstas pueden deberse no solo a la desactivación de estos factores antinutricionales, si no también, a otros efectos como lo son la desnaturalización de las cadenas proteicas y de almidón, volviéndolos menos refractarios a la acción enzimática (Kakade et al., 1973).
Efecto del desactivado de arveja con microondas sobre EMV y utilización de la energía
No se encontraron mayores diferencias entre cultivares de arveja, y tampoco entre campañas de cultivo (2019 y 2020). Los parámetros que más variaron fueron FC, FDN y FDA.

Efecto del desactivado con microondas
Pese a que la arveja presenta bajos niveles de factores antinutricionales, se encontró un efecto beneficioso al aplicar un proceso térmico empleando microondas, y se estableció que con 5 min de cocción al 70% de potencia en un microondas de 900 watts se logran los mejores resultados de EMV y utilización de la EB.
Bibliografía disponible en su versión online
Caracterización de arveja para la alimentación de aves y efecto del desactivado con microondas
DESCÁRGALO EN PDF

 S.Millet, M.Aluwé ILVO, Melle, Belgium
S.Millet, M.Aluwé ILVO, Melle, Belgium
Globalmente, la producción porcina se basa en un sistema intensivo centrado en la rentabilidad. La selección genética y la nutrición optimizada han reducido los costos por kg de carne de cerdo a lo largo de los años, permitiendo a los ganaderos producir en un mercado condicionado por los precios del mercado mundial.
Los recientes desequilibrios entre producción y consumo a escala mundial y los bajos precios concomitantes están evidenciando los límites del sistema
Puede ser necesario pasar de un modelo de comercialización basado en la oferta a otro basado en la demanda.
Esto requerirá la cooperación en toda la cadena con acuerdos claros entre todos los integrantes de la cadena (Millet et al., 2021 ).
Para producir en un mercado basado en la demanda, los productores deben responder a las expectativas de sus clientes sobre la forma de producir los animales.
La valoración de la carne de cerdo por parte del consumidor se basa en atributos de calidad , tanto extrínsecos como intrínsecos.
Los factores extrínsecos son:
Buen estado de salud y bienestar Impacto mínimo sobre el medio ambiente.
La calidad sensorial es un factor intrínseco importante.

Tanto los factores extrínsecos como los intrínsecos están influidos en cierta medida por la dieta de los animales.

Sin embargo, pueden observarse efectos contradictorios. Por ejemplo:
Uso de niveles farmacológicos de óxido de zinc (ZnO) es muy eficaz para combatir la diarrea del destete, pero la excreción de Zn es perjudicial para el medio ambiente.
Del mismo modo, unos niveles de fósforo suficientes son esenciales para una óptima mineralización ósea , pero una excreción excesiva de fósforo conduce a la eutrofización.
El aumento del contenido de grasa puede favorecer el sabor, pero disminuye la eficiencia.
de la dieta porcina para producir carne de cerdo aceptable
A continuación, analizamos estas y otras cuestiones fundamentales para producir una carne de cerdo aceptable…
Si bien los ingredientes de los alimentos para animales no actúan como productos farmacológicos, una alimentación correcta puede aumentar la resiliencia de los animales a enfermedades. Las deficiencias o los excesos en los niveles de nutrientes pueden predisponer a los cerdos a enfermedades.

Minerales como el fósforo y el calcio son cruciales para la salud de los huesos y las vitaminas (por ejemplo, la vitamina D) son esenciales para la inmunomodulación.
Vitamina D
El óxido de zinc a concentraciones “farmacológicas” (2500 mg/kg) ha demostrado ser eficaz en la lucha contra la diarrea postdestete aunque su mecanismo de acción aún no se conoce bien (Debski, 2016 ).

El uso de ZnO se prohibirá en la Unión Europea y se están buscando estrategias alternativas. Una de estas estrategias consiste en reducir el nivel de proteína bruta en la dieta,

ya que la proteína aumenta la capacidad tampón del estómago e incrementa el riesgo de fermentación de la proteína en el intestino grueso, con el incremento concomitante de metabolitos potencialmente tóxicos.
La disminución de los niveles de proteína bruta en la dieta puede reducir el riesgo de diarrea postdestete, pero al mismo tiempo puede disminuir el rendimiento de los animales, especialmente cuando los niveles de aminoácidos no están equilibrados.
De hecho, aunque los animales necesitan principalmente un conjunto de aminoácidos (esenciales), en un estudio reciente encontramos que a niveles de lisina SID: proteína bruta superiores al 6,4%, los aminoácidos esenciales pueden no ser utilizados de forma óptima (Figura 1, Millet et al., 2018).
Durante el periodo inmediatamente posterior al destete, puede ser una opción válida alimentar por debajo de los requerimientos para un crecimiento óptimo y así reducir el riesgo de alteraciones gastrointestinales.
El uso de este máximo de 6,4% puede evitar la inclusión de aminoácidos esenciales a niveles superiores a los utilizados para el crecimiento muscular.
0.05 0 2 4 6 8 10 12 14
0.055 0.06 0.065
SID Lys: PB
SID Lys= 10 g/kg
SID Lys= 11 g/kg BILL 10 g/kg BILL 11 g/kg BILL overall 0.07 0.075 0.08

Figura 1. Efecto de la ratio de lisina (Lys) estandarizada ileal (SID) y proteína bruta (PB) en la dieta sobre los niveles de urea sérica en lechones a las 7 semanas de vida. Se presentan los lechones que recibieron 10 u 11 g de SID Lys/kg de dieta, junto con sus correspondientes modelos de línea quebrada individuales así como el global. Las líneas verticales azules representan los puntos de ruptura. El nivel de urea en suero disminuye con el descenso del nivel de PB (=aumento de la relación SID Lys:PB) hasta alcanzar un mínimo. Esto indica el punto de máxima retención de nitrógeno y mínima degradación de proteínas. Una consecuencia lógica es que las dietas bajas en PB para lechones pueden contener niveles de aminoácidos por debajo de los requerimientos para un crecimiento y eficiencia máximos(Millet et al., 2018. The effect of crude protein reduction on performance and nitrogen metabolism in piglets (four to nine weeks of age) fed two dietary lysine levels1. J Anim Sci 96, 3824-3836. https://doi.org/10.1093/jas/sky254).Traducido y reproducido con permiso de Oxford University Press on behalf of the American Society of Animal Science.
Otros Términos y Condiciones: -Idioma: Español Territorio: Global -Prohibida su inclusión bajo una licencia Creative Commons o cualquier otra licencia de Acceso Abierto que permita su posterior reutilización. -La línea de crédito y los avisos de derechos de autor/descargo de responsabilidad proporcionados por OUP se incluirán en la misma página que el Material, traducido al idioma del nuevo trabajo, excepto los nombres de marcas registradas: Autor, título, revista, año, volumen, número de edición , paginación, número DOI. Traducido y reproducido con permiso de Oxford University Press en nombre de la Sociedad Estadounidense de Ciencia Animal. Descargo de responsabilidad de traducción: OUP y ASAS no son responsables de la precisión de la traducción. El licenciatario es el único responsable de la traducción de esta publicación/reimpresión.
Tanto los ingredientes como los alimentos completos se procesan para optimizar la digestibilidad de los nutrientes. Estos pasos de procesamiento pueden incluir:
La molienda
La expansión
La extrusión

La peletización
Todos estos procesos disminuyen el tamaño de las partículas de la dieta y, por tanto, aumentan la superficie disponible para las enzimas digestivas
El peletizado probablemente también disminuye el desperdicio de alimento.
Todos estos factores mejoran el rendimiento de la canal por kg de alimento. Sin embargo, estos métodos de procesamiento tienen un efecto negativo sobre la estructura del alimento, lo que es importante para el funcionamiento gástrico.
La falta de estructura resulta en una mayor fluidez en el estómago, lo que eventualmente conduce a un gradiente de pH menos definido en el estómago y a la formación de úlceras gástricas en la parte del esófago (Maxwell et al., 1970).
Muchos cerdos de engorde muestran algún nivel de lesiones en la mucosa gástrica , lo que constituye un problema potencial de bienestar. En el peor de los casos, este daño podría provocar úlceras gástricas y muerte súbita.
Por tanto, aportar estructura a la dieta puede mejorar la salud y el bienestar de los cerdos, aunque afecte negativamente a su rendimiento.
de la dieta porcina para producir carne de cerdo aceptable


Durante su crecimiento, los cerdos convierten la proteína vegetal en proteína animal.

Las dietas contienen ingredientes que son comestibles para el ser humano (especialmente cereales) y productos que no lo son, con una conversión de proteína comestible para el ser humano de aproximadamente 1 (Laisse et al., 2018 ).
Las dietas de los cerdos ya contienen grandes cantidades de subproductos, pero para satisfacer las expectativas de los clientes, es posible que la cadena porcina tenga que replantearse aún más el papel de los cerdos dentro de la economía circular.

La capacidad de los cerdos para convertir los subproductos de la cadena alimentaria en alimentos valiosos y en estiércol puede utilizarse para contribuir al suministro de alimentos para el ser humano, al tiempo que se reduce el impacto de toda la cadena alimentaria sobre el medio ambiente y el (Van Zanten et al., 2019).
Esto implica una reducción de los ingredientes comestibles para humanos, así como la utilización de tecnologías que mejoren el uso de los subproductos, como los aminoácidos libres y las enzimas.
El impacto negativo sobre el medio ambiente puede mitigarse:
Reduciendo el contenido de nitrógeno y fósforo de la dieta
Aumentando la eficiencia del uso del nitrógeno y el fósforo.
El uso de fitasa y aminoácidos libres es una práctica habitual en la actualidad y ha permitido reducir considerablemente la excreción excesiva de nutrientes.
Es necesario seguir investigando, especialmente en los cerdos de engorde, para conseguir nuevas mejoras.

En cuanto al impacto sobre el calentamiento global y el clima, la huella de carbono de los alimentos para cerdos contribuye en gran medida a la huella de carbono del producto porcino acabado.
Especialmente, la harina de soja vinculada a la deforestación tiene un gran impacto medioambiental (van Zanten et al., 2015 ).
Fósforo
La búsqueda de fuentes de proteínas alternativas está en marcha. El impacto de los nuevos ingredientes debe evaluarse mediante el análisis del ciclo de vida para garantizar un progreso real.

AUMENTAR LA EFICIENCIA DEL USO DEL NITRÓGENO Y EL FÓSFORO
Importancia de la dieta porcina para producir carne de cerdo aceptable

Hay varios aspectos que afectan a la calidad de la carne de cerdo.



Principalmente:
La jugosidad y la ternura influyen en la apreciación del consumidor.
Mientras que la capacidad de retención de agua de la carne de cerdo también es importante desde el punto de vista económico para garantizar una buena calidad del producto y evitar pérdidas.

Estas características están relacionadas con un contenido de grasa intramuscular suficientemente alto, una baja pérdida por goteo, una baja fuerza de corte y buenos valores de pH.
Se ha demostrado que alimentar a los cerdos con dietas deficientes en proteínas o en lisina, pero con la energía adecuada, aumenta:
Estas características están influenciadas por las condiciones de cría, manejo, sacrificio y refrigeración, así como la dieta de los cerdos. (Lebret, 2008)

Se considera que la suplementación con vitamina E y magnesio mejora la capacidad de retención de agua y el color.
Además, la calidad sensorial también puede mejorarse con la suplementación con vitamina E (Dugan et al., 2004; Ellis & McKeith, 2019).
Por último, se ha demostrado que la alimentación ad libitum en la fase de engorde, en comparación con la alimentación restringida, tiene efectos beneficiosos en cuanto al contenido de grasa intramuscular y la calidad sensorial.
No obstante, estas estrategias pueden implicar costos de eficiencia económica y medioambiental.
La carne de cerdo sigue siendo popular, pero las exigencias del sistema de producción están cambiando.

En las últimas décadas, los productores de cerdos han aumentado su eficiencia, lo que ha conducido a una intensificación de la producción porcina.
Ahora el sistema está bajo presión. Producir carne de cerdo para satisfacer las exigencias de los clientes requerirá cambios fundamentales en el sistema , apoyándose en los conocimientos sobre cómo aumentar la eficiencia, disminuir el impacto ambiental y mejorar la salud de los cerdos.
Importancia de la dieta porcina para producir carne de cerdo aceptable DESCÁRGALO EN PDF
de la dieta porcina para producir carne de cerdo aceptable


1 Universidad Autónoma de Yucatán, Facultad de Medicina Veterinaria y Zootecnia, Yucatán, México.
2 Universidad Nacional Autónoma de México. Facultad de Estudios Superiores Cuautitlán. Cuautitlán. México
Cualquier sistema de producción de ovinos y/o caprinos cuya fuente de alimentación esté basada en la utilización de pasturas se enfrenta invariablemente a la presencia de nematodos gastrointestinales
Rafael Arturo Torres-Fajardo 1; Rosa Isabel Higuera-Piedrahita2En la actualidad, la infección ocasionada por los NGI sigue siendo considerada como la mayor amenaza sanitaria para los rebaños de ovinos y caprinos, lo cual repercute negativamente en la viabilidad y la rentabilidad de dichos sistemas de producción (1,2)
Esta situación se ve potenciada por la aparición de cepas de NGI resistentes a los antihelmínticos (AH) convencionales (3,4) e incluso, a los principios activos de más reciente introducción en el mercado (5,6,7,8)
Dentro de este abanico de estrategias se puede mencionar:
El uso racional de AH (11,12)
La suplementación nutricional (13,14)

La selección genética (15,16)
La inmunización (17,18)
El uso de agujas de óxido de cobre (19,20)
La rotación de praderas (21)
El bio-control (22,23)


Se estima que las pérdidas ocasionadas por la infección con NGI y sus costos asociados son —en promedio— de 151, 206 y 86 millones de euros en ovinos lecheros, de carne y caprinos lecheros, respectivamente

Con la intención de generar no-farmacológicas los altos índices de resistencia de los NGI hacia los AH, se han propuesto diversas estrategias, las cuales se han encasillado bajo el término de nematodos gastrointestinales.
Y el estudio de las propiedades AH de algunas especies de plantas (24,25,26) .


Invariablemente, todas las especies de plantas producen diferentes cantidades y concentraciones de ciertos elementos que poseen múltiples funciones biológicas, conocidos como metabolitos secundarios de las plantas (MSP).
Debido a la heterogeneidad en su composición química, existen muchos métodos de clasificación, sin embargo, de manera muy general se han establecido tres grandes grupos funcionales:
Alcaloides: Esta familia de MSP posee unas 20,000 estructuras identificadas
Compuestos fenólicos: Dentro de este grupo, los taninos condensados han recibido una atención especial debido a su actividad AH y su presencia en varias especies de plantas (43,44,45)
La producción de MSP depende de:
La exposición de la planta a la luz Temperatura Estrés
Y características específicas del
Terpenos: Representan el grupo más numeroso de MSP con unas 80,000 estructuras identificadas (46) y cuya actividad AH es el motivo de la presente revisión.
Estos MSP hacen parte del grupo más diverso y complejo desde el punto de vista químico y estructural.
De manera general, los terpenos son sustancias volátiles mayormente responsable del olor de muchas plantas y frutas.
Los Aceites Esenciales (AcEs) son muy heterogéneos en su composición química y en la multitud de propiedades que se les han atribuido en diversas actividades como las industrias farmacéutica, cosmética, veterinaria y pecuaria.
A pesar de su nombre, no son aceites verdaderos. De igual manera, el término esencial no se refiere a una propiedad determinante, sino a que son derivados de componentes responsables de la fragancia o quinta essentia de las plantas (52)
Los AcEs pueden obtenerse de diversos recursos vegetales (hojas, flores, tallos, frutos, vainas, semillas, raíces y cortezas) o animales (organismos marinos) y representan mezclas lipofílicas que contienen una variedad de compuestos químicos.

Por lo tanto, podríamos considerar a los AcEs como sustancias oleosas que contienen diferentes tipos de MSP.
Finalmente, a pesar de que sus efectos bioactivos pueden ser atribuidos a los componentes mayoritarios, las sinergias entre diversos MSP deben ser consideradas y estudiadas.

Es necesario recalcar que aún no existen guías oficiales para determinar la eficacia de productos naturales en rumiantes.
En consecuencia, los trabajos realizados hasta la fecha han empleado las guías oficiales para determinar la efectividad de productos sintéticos (73) o algunas publicaciones realizadas por expertos en la materia (74)
Como resultado de la búsqueda de estrategias no farmacológicas para enfrentar la resistencia AH y a los NGI, se han documentado las propiedades AH tanto de los terpenos (59,60) como de los AcEs (61)
Las pruebas in vitro presentan un bajo costo, mayor rapidez en los resultados y otorgan la posibilidad de examinar un número relativamente amplio de materiales en un periodo corto de tiempo (75)
Sin embargo, estas pruebas no se enfrentan a la naturaleza multifactorial de la fisiología animal en la cual:
Existe una dinámica en las cantidades y concentraciones de químicos que ingresan al sistema digestivo
La tasa y secuencia en la que los MSP ingresan y son procesados es variable y dinámica
Se requeriría de consumos elevados de material vegetal fresco por parte de los animales para igualar las concentraciones que arrojaron resultados positivos en condiciones in vitro
Las poblaciones microbianas del rumen tienen la capacidad de desarrollar adaptaciones a los MSP.

Para el desarrollo del enfoque in vivo en la evaluación de la actividad AH de productos naturales se pueden implementar dos metodologías (72)
Test de reducción del conteo fecal de huevos de NGI (TRCFH):

Se administra el material bioactivo a un grupo de animales y se hace seguimiento cuantitativo de la excreción de huevos por gramo (HPG) de NGI en un periodo de tiempo (pre y pos).
Test controlado (TCn):
Presenta los mismos fundamentos del TRCFH, pero con la obligatoriedad de establecer un grupo control y de realizar sacrificios humanitarios a los animales con el objetivo de recuperar los órganos del tracto gastrointestinal donde se alojan los NGI adultos.
Posteriormente se deben realizar conteos de las poblaciones de NGI al igual que mediciones en los NGI recuperados, lo que permite una comparación entre grupos experimentales. Por lo tanto, debido a la dificultad de duplicar estos factores, evaluar en el huésped es la mejor alternativa para determinar el valor AH de plantas y sus derivados (75)
Esta metodología, a pesar de ser más costosa y necesitar mayor mano de obra, es la más confiable para evaluar la actividad AH de un producto natural.
El TRCFH fue utilizado en todos los trabajos incluidos en la presente revisión. Los resultados de la dinámica en las cuentas de HPG tras la administración de PRT o AcEs fueron variables, mostrando actividades que pueden clasificarse como:
Nulas (62,66,69)
Moderadas (63,67,68)
Positivas (64,70)
Sobresalientes (65)
Si bien estas respuestas en la dinámica de la infección por NGI provienen de un número reducido de trabajos y son ciertamente ambiguas, nos permiten encontrar un potencial en la administración de estos recursos con fines terapéuticos en pequeños rumiantes.
En los trabajos de Ketzis et al. (62) y Katiki et al.(66), la administración
Resultados significativos fueron reportados por Camurca et al.(61) quienes mencionan cierto nivel de selectividad del AcEs de Lippia sidoides sobre las poblaciones de Haemonchus contortus.
Asimismo, el AcEs de losfrutos de Zanthoxylum zanthoxyloides (70) y una solución encapsulada de los terpenos anetol y carvona (72) disminuyeron:

El número de NGI adultos
El tamaño de los machos
Y el número de huevos producidos por hembra
Los mecanismos de acción por los que los terpenos o AcEs afectan a los NGI aún son inciertos.
Sin embargo, se ha propuesto que, debido a su naturaleza hidrofóbica, la membrana celular es el objetivo
Estos compuestos ingresan a las estructuras de los NGI a través de difusión transcuticular, interfiriendo con el metabolismo e impidiendo funciones vitales, incluso afectando algunos mecanismos de locomoción (77) .
De acuerdo con López y Pascual-Villalobos (78), los AcEs presentan actividad hacia los receptores de acetilcolinesterasa presentes en vertebrados e invertebrados produciendo un daño neurotóxico similar a los organofosforados.
Sin embargo, resulta importante recalcar que la bioactividad de terpenos y AcEs sobre otros organismos puede ser tan amplia y diversa como su elevado número de moléculas identificadas.

La investigación y el desarrollo de productos naturales con propiedades AH ha surgido como una respuesta hacia las crecientes poblaciones de NGI resistentes a los AH comerciales.
Durante esta revisión, la existencia de poblaciones de NGI resistentes a la ivermectina se hizo evidente, al reportar reducciones en la eliminación de HPG del orden de 67 - 85% (63) , 35 – 54% (62) y 25% (67)
El estudio de estas variables parasitológicas se puede ver complementado con el seguimiento de variables fisiológicas y variables productivas como la ganancia diaria de peso (GDP) y la conversión alimenticia.
En este sentido, Whitney et al. (67) reportan una disminución en la ganancia de peso tras la inclusión del 30% de Juniperus pinchotii en una dieta balanceada en cordero.
Por su parte, Azando et al. (70) reportan que la administración del AcEs de los frutos de Z. zanthoxylum no afectó la GDP ni el peso vivo final de corderos.
En este sentido, a pesar de que los resultados tienden a indicar una afectación en las variables productivas, futuros trabajos deben establecer la relación costo-beneficio entre nutrición y sanidad (79-80)
Actualmente se han identificado unas 80,000 plantas que ejercen alguna influencia sobre la salud y la productividad animal (82), por lo tanto, resulta necesario conocer la naturaleza de sus interacciones con los herbívoros y de esta forma poder sugerir su uso como recursos que representen un beneficio nutricional y farmacéutico en los sistemas de producción de ovinos y caprinos (83,84)
Estos beneficios podrían estar representados en los denominados alimentos funcionales o recursos nutracéuticos.
Control integrado de nematodos gastrointestinales en pequeños rumiantes DESCÁRGALO EN PDF
Futuras investigaciones podrían realizarse considerando factores que pueden influenciar las propiedades bioactivas de los recursos naturales como la dosis, biodisponibilidad, época de recolecta de las especies de plantas, método de extracción de MSP o AcEs, presencia de otros MSP e interacciones entre MSP.
De igual manera se deben considerar factores relacionados con los animales como la vía de administración, comportamiento productivo, plano nutricional, estado fisiológico y nivel de adaptación a MSP.
Bibliografía disponible en la versión on line Este artículo fue publicado en la revista MVZ Córdoba 2021; septiembre-diciembre. 26(3):e2317. https://revistamvz.unicordoba.edu.co/article/view/e2317

